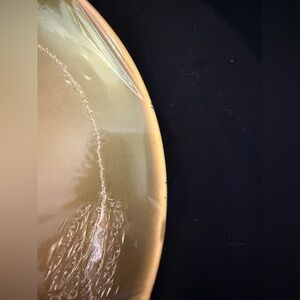

Vintage Betty Boop "Ready for Duty" 12" Tin Sign
NWT
$15
Size
Like and save for later
Add To Bundle
Round tin sign featuring Betty Boop in a patriotic swimsuit. The sign was produced in 1998 by King Features Syndicate and Fleischer Studios. Perfect for fans and collectors.
This is brand new with the plastic still on it. On the back there is very minor paint missing just from it sitting over time (see photos). Comes from a smoke free home.
Shipping/Discount
Trending Now
Find Similar Listings
Account is under Review
Comment posting is temporarily restricted. Our team will reach out to you shortly. To understand why, select
Learn More.